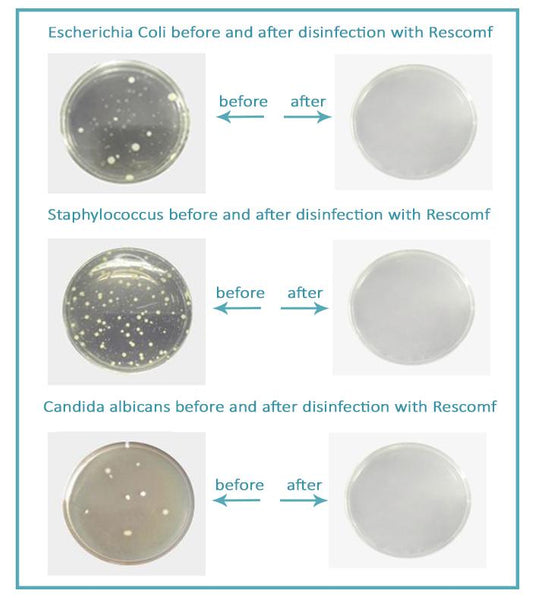

Easily and Efficiently Sanitize and Clean your CPAP without Removing the Mask, Hose, or Reservoir.
The CPAP Cleaner And Sanitizer take the daily hassle out of cleaning your CPAP equipment. Simply press start button and you’ll get sanitization in 30 minutes with 99.9% of bacteria and other pathogens eliminated. No disassembly. No water. No chemicals. It is so easy to use that you won’t even have to set timers on the machine. Just enjoy the 1-click automatic cleaning cycle!
The CPAP Cleaner And Sanitizer's innovative technology automatically completes this daily chore of sanitizing without any disassembly. It uses this activated oxygen (Ozone) to eliminate any mold, bacteria, and viruses it comes in contact with—safely and effectively.
Now, with the CPAP Cleaner, a waterless CPAP cleaning alternative, your patients can properly clean their CPAP/Bi-Level device and equipment! To use this device, simply plug in your CPAP/Bi-Level to the CPAP Cleaner, turn the CPAP Cleaner on, and walk away. The CPAP Cleaner will automatically clean your system using Ozone, also known as activated oxygen, in only 30 minutes.
WHY OUR CPAP CLEANER AND SANITIZER
Sanitize all of your entire CPAP equipment without removing the mask, hose, or reservoir.
- Automatic Cleaning
- Kills 99.99% of germs and bacteria in only 30 minutes!
- Requires no soap, water, or cleaning solutions
- Small and portable, weighing only 8 ounces
- Ultra-quiet
- Uses Ozone (activated oxygen) to disinfect
- 10 year Battery life
- Charging time only 2 hours
- Requires no maintenance
- Ideal for homecare, but can be used to clean multiple masks in a hospital setting.
HOW TO USE CPAP CLEANER & SANITIZER:
Step 1: Clean Your Mask and Hose.
1. For a non-heated hose : With mask attached, plug your hose into your CPAP machine
2. For a heated hose : detach your mask and plug the end of the hose that usually attaches to the mask into CPAP Cleaner
3. Turn the Cleaner on and wait 30 minutes. The machine will beep 5 times when the cleaning cycle is complete, and then turn itself off.
4. If you have a humidifier, dump out any water.
5. Reconnect the hose to the humidifier (which is attached to the CPAP machine) or if you do not have a humidifier, reconnect the hose to the machine. Turn on CPAP Machine and wait 30 minutes.
Recommended by:
PACKAGE CONTENTS :
- CPAP Cleaner And Sanitizer machine;
- USB Charger Cable;
- Can I Buy It In-Store?
No, Offer Not Available In Stores. - Where are you located?
We are located in California. - Do you provide tracking number?
You will receive end to end tracking number with your order. - Do you have a Money Back Guarantee?
Yes, 30-Day Money Back Guarantee. - Do you have a safe checkout?
Yes, McAfee™ and SSL secured checkout.
Shipping & Handling
USA Orders FREE: Your order will be delivered 3-15 business days after being dispatched. USPS/DHL tracking number will be provided.Please allow 2-3 business days for handling due to high demand.OUR GUARANTEE
We truly believe we have some of the best products in the world, and we want to make sure we back that up with a risk-free ironclad 30-day guarantee. If you don't have a positive experience for ANY reason, we will do WHATEVER it takes to make sure you are 100% satisfied with your purchase.
Buying items online can be a daunting task, so we want you to realize that there is absolutely ZERO risk in buying something and trying it out. If you don't like it, no hard feelings we'll make it right.
We have 24/7/365 Ticket and Email Support. Please contact us if you need assistance.